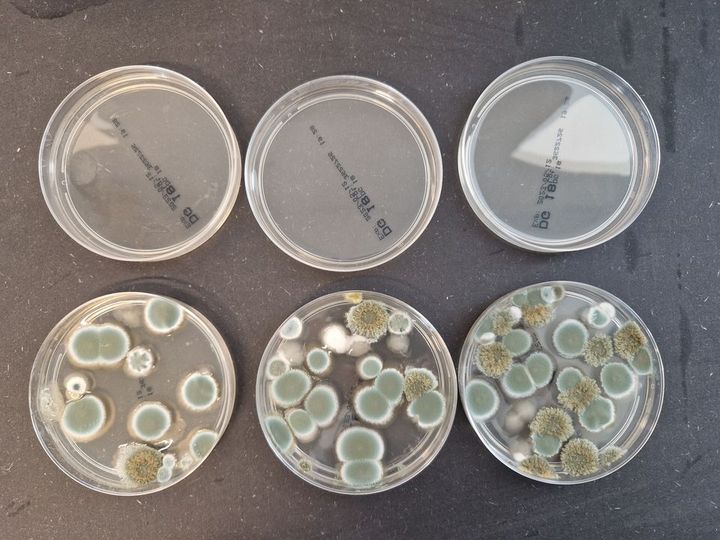

Far-UVC lys beskytter hospitaler mod skimmel – ny teknologi nu tilgængelig i Danmark
UV Medico introducerer Far-UVC 222 nm teknologi i Danmark, der beskytter hospitaler mod skimmel. Denne innovative løsning sikrer sundt indeklima uden at forstyrre driften, ideel til hospitaler pga. sikker desinfektion. Teknologien, dokumenteret og udbredt globalt, er udviklet i samarbejde med Aarhus Universitet.
Skimmel i hospitalsbygninger er et voksende problem, der truer både patientsikkerheden og bygningsdriften. Fugt, ventilationssystemer og ældre konstruktioner skaber ideelle forhold for vækst af skimmelsvamp, som kan have alvorlige konsekvenser for patienter med svækket immunforsvar.
Nu bliver den internationalt anerkendte Far-UVC 222 nm teknologi for første gang tilgængelig i Danmark gennem den danske virksomhed UV Medico, som bringer løsningen ind på hospitaler og i andre kliniske miljøer.
Skimmel – en skjult sundhedsrisiko på hospitaller
Selv små mængder skimmel kan frigive sporer og toksiner, som kan:
- Øge risikoen for infektioner hos sårbare patienter
- Forværre astma og luftvejssygdomme hos både personale og patienter
- Medføre dyre nedlukninger og saneringer i hospitalsafsnit
”Skimmel i hospitalsmiljøer er ikke kun et bygningsproblem – det er et sundhedsproblem. Far-UVC giver hospitaler en ny mulighed for at forebygge vækst og sikre et sundt indeklima uden at forstyrre driften,” siger Peter Johansen, CEO hos UV Medico.
Sikker og kontinuerlig desinfektion med lys
Far-UVC-lys ved 222 nanometer dræber mikroorganismer som skimmelsporer, bakterier og virus – men trænger ikke gennem hud eller øjne. Det gør teknologien sikker til brug i rum med mennesker, og dermed ideel til hospitaler, operationsgange, patientområder og teknikrum.
Løsningen kan:
- Forebygge skimmelvækst i fugtige og utilgængelige områder
- Reducere luftbårne infektioner kontinuerligt
- Minimere brugen af kemiske rengøringsmidler og energi til udtørring
Far-UVC kan integreres i eksisterende loftsbelysning eller installeres som selvstændige enheder, der arbejder automatisk og lydløst.
Dokumenteret teknologi – udbredt på hospitaler verden over
Far-UVC er allerede udbredt på hospitaler verden over, hvor teknologien anvendes til at reducere mikroorganismer og forbedre luftkvaliteten i kliniske miljøer.
UV Medico har i dag mere end 13.000 installationer globalt, hvilket understreger teknologiens pålidelighed, effektivitet og modenhed.
Den danske version af teknologien er udviklet i samarbejde med Aarhus Universitet og bygger på international forskning, der dokumenterer både sikkerhed og effekt.
”Vi er stolte af at bringe denne teknologi til Danmark og gøre den tilgængelig for danske hospitaler og sundhedsbygninger,” siger Peter Johansen.
En investering i sundhed og driftssikkerhed
Med stigende fokus på indeklima og infektionskontrol bliver Far-UVC en ny og vigtig del af hospitalernes forebyggende vedligehold.
Teknologien giver sundhedsvæsenet mulighed for at:
- Beskytte patienter mod skimmelrelaterede infektioner
- Forlænge levetiden på bygninger og installationer
- Sikre kontinuerlig desinfektion uden driftsafbrydelser
Nøgleord
Kontakter
Søren RohdeChief Marketing Officer
Søren er ansvarlig for alle presserelaterede aktiviteter i UV Medico.
Links
UV Medico A/S
UV Medico er en aarhusiansk virksomhed, der er markedsledende i Far-UVC teknologi i 222 nm. Vi forsker i teknologiens muligheder og udvikler produkter, der bruges i medicinalindustrien og sundhedssektoren.
Følg pressemeddelelser fra UV Medico A/S
Skriv dig op her, og modtag pressemeddelelser på e-mail. Indtast din e-mail, klik på abonner, og følg instruktionerne i den udsendte e-mail.
Flere pressemeddelelser fra UV Medico A/S
World Premiere at MEDICA 2025: UV Medico Launches Revolutionary Instrument Table Light Designed to Reduce SSIs12.11.2025 17:23:22 CET | Press release
Aarhus, Denmark – At this year’s MEDICA in Düsseldorf, UV Medico unveils its latest innovation: the Instrument Table Light, a breakthrough Far-UVC solution designed to reduce surgical site infections (SSIs) by targeting one of the most overlooked contamination sources in the operating room; the instrument table.
Verdenspremiere på MEDICA 2025: UV Medico lancerer revolutionerende Instrument Table Light, udviklet til at reducere SSIs12.11.2025 17:23:22 CET | Pressemeddelelse
Aarhus, Danmark – På dette års MEDICA i Düsseldorf præsenterer UV Medico sin nyeste innovation: Instrument Table Light, en banebrydende Far-UVC-løsning udviklet til at reducere operationssårinfektioner (SSI’er) ved at ramme en af de mest oversete kilder til kontaminering i operationsstuen: instrumentbordet.
Ny forskning: Ny type ultraviolet lys er en effektiv løsning mod skimmelsvamp16.12.2024 12:00:00 CET | Pressemeddelelse
Skimmelsvamp er et tilbagevendende problem på flere af landets hospitaler. Ny forskning viser, at en mulig løsning allerede er tilgængelig. En ny lystype, der hedder Far-UVC, kan holde skimmelsvamp væk og er sikker at anvende på steder, hvor der er mennesker til stede.
I vores nyhedsrum kan du læse alle vores pressemeddelelser, tilgå materiale i form af billeder og dokumenter samt finde vores kontaktoplysninger.
Besøg vores nyhedsrum